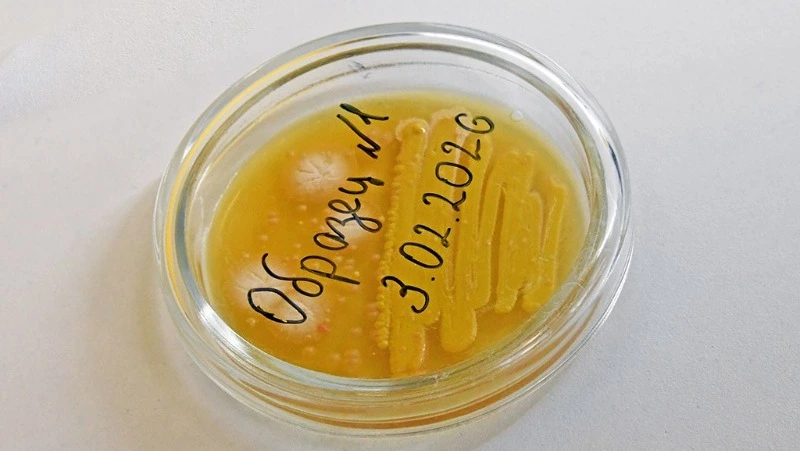

Ротавирусная инфекция — повсеместно распространённое высококонтагиозное вирусное антропонозное инфекционное заболевание, характеризующееся поражением желудочно-кишечного тракта с развитием ротавирусного гастроэнтерита. Опасность заключается в способности вызывать сильное обезвоживание организма из-за потери жидкости со рвотой и диареей. Заболеваемость регистрируется среди всех возрастных групп, но наиболее часто болеют дети младшего возраста, посещающие организованные детские коллективы.
Основной источник ротавирусной инфекции — больной человек в конце инкубационного периода и в первые дни болезни, а также вирусоносители. Механизм передачи возбудителя — фекально-оральный. Пути передачи: контактно-бытовой (через грязные руки и предметы обихода), водный (при употреблении воды, в которой присутствуют вирусы), пищевой, реже — воздушно-капельный путь.
Начало, как правило, острое, все симптомы заболевания развиваются в течение первых суток. Острый период болезни длится четыре-пять суток, период выздоровления — три-пять суток. Заболевание чаще всего начинается остро с повышения температуры тела 37,5-38,5 °С, появляются симптомы интоксикации (вялость, слабость, снижение аппетита). Ведущими в клинической картине заболевания являются симптомы со стороны желудочно-кишечного тракта: жидкий стул, повторная рвота, боли в животе, часто наблюдаются симптомы острого респираторного заболевания, которые могут наблюдаться как до развития кишечного синдрома, так и одновременно и после его развития. В зависимости от возраста и состояния здоровья ротавирусной инфекцией болеют с различной степенью тяжести. Во время острой фазы заболевания может наступить обезвоживание организма, что чревато необратимыми последствиями.
Есть и другие кишечные инфекции со схожими симптомами, которые различить сможет только специалист. Поэтому не теряйте драгоценного времени, обращайтесь к врачу. Точно установленный диагноз и своевременно принятые меры помогут подобрать правильное лечение.
Чтобы предотвратить заражение ротавирусной инфекцией, не забывайте основные меры профилактики:
- соблюдение личной гигиены (мытьё рук, использование кожных антисептиков);
- использование для питья кипячёной или бутилированной воды;
- тщательное мытьё овощей, фруктов, ягод, особенно употребляемых в сыром виде;
- не покупайте продукты питания в местах несанкционированной торговли;
- купание только в предназначенных для этого водоёмах, не допуская попадания воды в рот;
- при возникновении в семье заболевшего ротавирусной инфекцией необходимо изолировать больного, обеспечить личной посудой, полотенцем;
- своевременно обращаться за медицинской помощью при появлении первых признаков заболевания взрослым, не заниматься самолечением.












